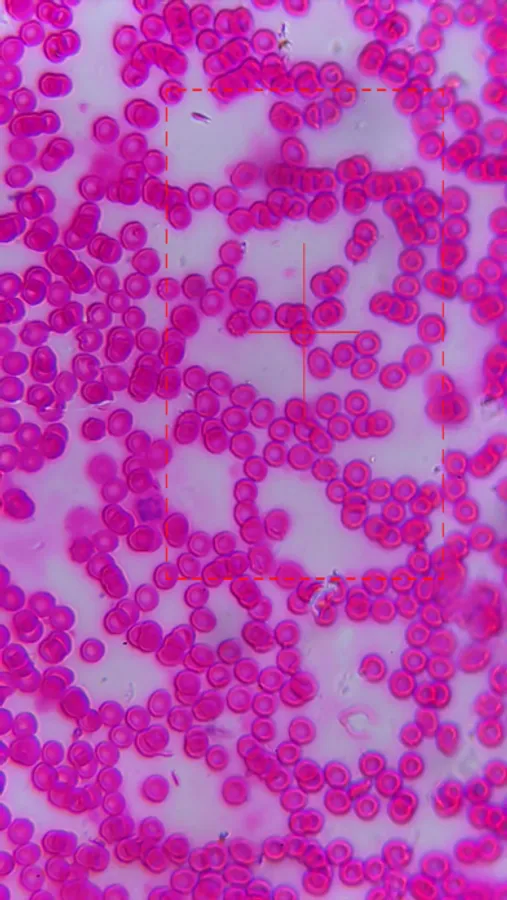

About M-Scope
M-Scope is a software that supports corresponding intelligent microscope. It is connected to microscope devices through WiFi, providing functions such as observation, photography, video recording, and recording observation notes. It also supports downloading materials to local management, providing operators with convenient and efficient observation tools.
M-Scope Screenshots
Tap to Rate: